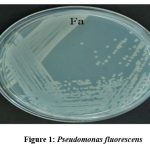

Introduction
Agriculture output must increase by 50% to support the world’s nine billion people, whose population is rapidly expanding1 by 2050. Leaving aside any potential compensation from rising levels of carbon dioxide (Co2), 17% is the agricultural output in response to climate.20 Climate change not only lowers crop yield but raises the price of agricultural products, raising the likelihood of 77 million people experiencing food poverty by 2050.11 The objective is to improve soil health by sequestering soil carbon and mitigate harsh climatic circumstances24 by increasing the production of nutritious food while decreasing unsustainable inputs. Sustainable practices and adopting environmentally friendly technology can help break this feed-forward loop in such a scenario by enhancing production under a variety of more harsh environmental conditions and improving resource usage efficiency.8 The plant-influenced areas with the highest levels of microbial diversity28 are roots, root surfaces, and cellular space in between plant cells; these areas are known as the rhizosphere, rhizoplane, and endosphere; they are essential for carbon sequestration and phytoremediation.8,6 Given that microbial abundance can influence greenhouse gas emissions, the composition of the bacterial community is significantly associated with soil features across the ecosystem.9 Furthermore, through their metabolic activities, the bacteria in the rhizosphere contribute significantly to the practical cycling of carbon between the soil and the atmosphere.3
Microbial abundance and diversity in rhizosphere are influenced by host plants and soil characteristics.26 Recently, the signal exchange part of this synergistic interaction has come into prominence. The quantity and behavior of plant-associated bacteria are influenced by root exudates, which contain organic acids, sugar, vitamins, and other compounds.10 According to,22 microbe-to-plant signals are necessary for the growth of host plants. Chemical fertilizers can be excluded by using phytomicrobiomes (microbial inoculation and signal exogenous administration) which produce a higher, robust and sustainable agricultural manufacturings.
Brinjal or Eggplant (Solanum melongena L.), a member of the Solanaceae family, is cultivated around the world in subtropical and tropical climates. One of the most widespread, productive, and well-liked vegetable crops in India. It has a good reputation as a poor man’s crop. In India and China, the unripe fruit of the aubergine is predominantly used as a daily kitchen vegetables for numerous meals. There are claims that brinjal has therapeutic qualities against disturbances and diseases like gastro intestinal problems, Skin related irritations, dental aches and hemorrhoids are treated by using various plant components. The secondary production of brinjal is by India preceding by China. The estimated volume of production according to the year 2023 is 12.61 million metric tons. 760 thousand hectares of agricultural land were utilized for the production. In Odisha, the production of brinjal is 2,128.52 tons/ha. Since it is widely held that brinjal is not a particularly for health benifits. However, it is comparable to tomatoes in terms of nutritional value and is relatively high. For greater growth, fruit, and seed yield, solanaceous vegetables often need substantial quantities of the secondary minerals calcium and sulfur, as well as the key nutrients nitrogen, phosphorus, and potassium. The price of inorganic fertilizer has been skyrocketing, making it unaffordable for small and marginal farms while also continuously degrading the ecological Raghvendra niche.27 Application of biofertilizers can increase soil biological activity, a key indicator of soil fertility.30 The present investigation was designed to determine a class of helpful bacteria called plant growth-promoting rhizobacteria (PGPR) that may hydrolyze both organic and inorganic phosphorus from insoluble substances. Pseudomonas fluorescens is advantageous and cost-effective for crop productivity, quality, yield, and growth.
Materials and Methods
Rhizospheric Site and Bacterial Isolation
Healthy vegetable plant rhizosphere soil samples were gathered from several sites in Kerala, India. We used the conventional serial dilution method to isolate the microorganisms. One gram of soil from the root portion was appropriately cleaned out and added to 9 mL of sterile physiological saline Himedia (pH 7.2), vortexed for 10 minutes, and left to rest for 20 minutes. A 100µl aliquot of each successively diluted soil suspension was then distributed onto the surface of nutrient agar plates and cultured for two to three days at 30 ± 2°C. To obtain pure colonies, distinct colonies were chosen, subcultured on a nutrient agar plate, Himedia, and then preserved in 20% glycerol solutions at -20°C. For additional research, P. fluorescens isolates with distinctive colony shapes were chosen.
Genomic DNA Isolation of P. fluorescens by Phenol Chloroform method
The chosen isolates underwent an overnight culture, were centrifuged for 10 minutes at 13,000 rpm, and the supernatant was disposed of carefully. Two additions were made: twenty microliters of proteinase K (50 micrograms per millilitre) and two millilitres of cell lysis buffer, all vortexed. The tubes were kept in a water bath at 55°C for fifteen minutes (microtubes were fixed with parafilm; Samarath Electronics, India). After adding 220 µl of PCI solution (saturated phenol, chloroform, and isoamyl alcohol; 25:24:1), the tubes were rolled between the palms to combine the mixture. After 15 minutes of centrifuging the tubes at 13,000 rpm, the top layer was removed and placed in fresh microtubes. Once more, 220 µl of PCI solution was added, and centrifugation was repeated briefly at 13,000 rpm for fifteen minutes. A fresh microtube was used to collect the top layer. A comparable dosage of chloroform was applied to the top layer. After 15 minutes of centrifuging the tubes at 13,000 rpm, the fluid stage was collected and transferred to fresh microtubes. Included was a two-fold amount of cooled absolute alcohol, which was kept overnight in a refrigerator set at -20 °C (1-2 hours). The tubes were centrifuged for 20 minutes at 13,000 rpm to get a DNA pellet, and the supernatant was discarded. The pellet obtained following centrifugation at 13,000 rpm for 10 minutes was washed with 300 µl of extremely cold 70% alcohol. After laboriously pouring off the ethanol, it was dried in an incubator at 37°C for 30 to 45 minutes (Microsil, India). After adding 50 µl of hydration buffer (1x MilliQ TE), it was allowed to rehydrate at room temperature for ten minutes before being stored in a 4°C refrigerator. Electrophoresis by 0.8% agarose gel was done to measure and examine the amount and quality of DNA in Lab India Analytical’s spectrophotometric analysis.
Primer Designing/Synthesis
Using the Primer-BLAST tool offered by NCBI with these sequences as targets, primers were created. BLAST analysis was used to evaluate the specificity of the primers. Eurofins Genomics, based in Bangalore, India, creates custom-designed primers. The sequence data thus obtained was further subjected to BLAST analysis.
Table 1: Primers used for PCR analysis along with their annealing temperatures
|
Gene |
sequence |
Annealing temperature (°C) |
Time
|
|
|
Pyoluteorin (plt) |
plt-F |
5‟ – CAACGGCTGTTGCTGATG -3‟ |
56°C |
40 sec |
|
plt-R |
5‟- GTGCCCGATATTGGTCTTGA-3‟ |
|||
|
ACC Deaminase Gene |
ACC-F |
5′- GTTATCCATTGACCTTCGGTCCT -3′ |
59°C |
40 sec |
|
ACC-R |
3′ – TTCGTTGGGCAAGCCATATT – 5′ |
|||
Effect of P. fluorescens & S. platensis on growth parameters of S. melongena L.
Seed Inoculation
A pure culture of P. fluorescens was cultured in NB broth for inoculating seeds. Before being washed ten times in sterile water, the seeds were surface sterilized for ten minutes in 1.2% sodium hypochlorite and two minutes in 70% ethanol. Afterwards, the seeds were kept sterile and exposed to the bacterial solutions for 30 minutes.
Immobilization using sodium alginate beads
A loop of culture was added to 200mL of LB broth Himedia to create the microbial culture, which was then cultured for one day at 28°C. Then, 4 g of sodium alginate Himedia was dissolved in 100 mL of distilled water while being continuously stirred at 60°C for one hour to create 4% sodium alginate. Microbial culture was combined in a 1:2 ratio with sodium alginate. It was then dipped into a 0.2M calcium chloride solution to create sodium alginate beads that contained the microbial cell. The beads were left to harden for 30 minutes. Then, three beads were put around each plantlet.
Effect of P. fluorescens & S. platensis. on the growth of S. melongena L.
With four treatments, three replications, and dispersed pots in the following configurations, the experiment was fully randomised: T1; soil with seeds of S. melongena (control), T2; soil with seeds added with NPK fertilizer (100%), T3; seeds and soil with P. fluorescence administered in the form of immobilized cells (100%), and T4; seeds and soil with S. platensis, a cyanobacteria (100%). Plants were carefully removed from the pots after maturation and biometric measurements such as root length, shoot length, fresh weight, fruit weight, number of fruits, dry weight, and fresh/dry weights of the plant were recorded.
Statistical Analysis
The variability in impact of various treatments and control condition on parameters like shoot length, root length, total length, wet weight, dry weight, (wet – dry) weight, number of leaves was statistically analysed using R version 4.0. All statistical analysis was conducted at 95% level of significance. Normally distributed variables were assessed using parametric test like ANOVA supplemented with TUKEY HSD post-hoc test. Non-normal variables were analysed using non-parametric equivalent of ANOVA like Kruskal Wallis test supplemented with a post-hoc analysis. All assumptions were checked on the variables prior the ANOVA test.
Result
Plant growth-promoting rhizobacteria (PGPR): Isolation and Screening
From different rhizospheric soils strains of rhizobacteria were purified, after being isolated and were then tested for various traits that promote plant growth (PGP). P6- Fa- were discovered to be very positive during the screening for IAA formation. For sample Fa, BLAST analysis showed a 100% similarity with P. fluorescens (NCBI Accession No: MN173420.1) with a query coverage of 100.
|
Figure 1: Pseudomonas fluorescens |
Identification of Plant growth Promoting Gene(s) by PCR in P6
The presence of the Pyoluteorin (plt) Gene and ACC Deaminase Gene in the isolated P6 strain was identified by PCR. The agarose gel electrophoresis analysis of the PCR for the Pyoluteorin (plt) Gene revealed the formation of the expected 591 bp product. This was further confirmed by the DNA sequence analysis where the sequence of the isolated P6 showed 99.83% identity to the PLT gene of P. fluorescens strain. The agarose gel electrophoresis analysis of the PCR for the 1-aminocyclopropane-1-carboxylate deaminase gene revealed the formation of the expected 629 bp product. This was further confirmed by the DNA sequence analysis where the sequence of the isolated P6 showed 100% identity to the P. fluorescens gene for 1-aminocyclopropane-1-carboxylate deaminase.
 |
Figure 2: PCR amplification of genes from P6, Lane1- PCR product of Pyoluteorin (plt) Gene Lane 2- Marker: Lambda DNA/EcoR1 plus Hind III Double digest marker, Lane 3- PCR product of ACC Deaminase gene |
 |
Figure 3: BLAST analysis of plt gene sequence, Accession number:ON000620 |
 |
Figure 4: BLAST analysis of ACC gene sequence, Accession number:ON000621 |
Effect of selected PGPR P. fluorescens on soil nutrient enhancement compared with chemical fertilizer in the growth of S. melongena L.
To analyze the impact on S. melongena L., an isolate with a history of consistently stimulating growth and possessing the majority of PGP qualities was chosen. The length of the shoot and root, the number of fruits, the weight of fruit, the fresh and dry weights of the plant, and the fresh-dry weights were monitored after maturation. Following the inoculation with P. fluorescens cell suspension and bead-encapsulation results in more biomass and fruit yield in comparison to the control plants
Descriptive Statistics
Stem Length
A significant variability in stem length among plants when treated with different treatments (F(3,116)= 21.247, p<0.001). Plants treated with encapsulated P. fluorescens 100% showed significantly (p<0.001) higher stem length compared to S. platensis 100% and significantly (p<0.001) lower stem length than control. NPK showed significantly (p<0.001) lower stem length than the control and higher (p<0.008) stem length than S. platensis 100%. Other treatments showed no significant variability in stem length.
 |
Figure 5: Stem Length vs Different Treatments |
Root Length
No statistically significant variability was detected in root length among plants when treated with different treatments.
 |
Figure 6: Root Length vs Different Treatments |
Number of Fruits
A statistically significant (p<0.001) variability in the number of fruits among plants when treated with different treatments. Plants treated with control showed a significantly (p<0.001) lower number of fruits compared to NPK and encapsulated P. fluorescens100%. Plants treated with NPK showed a significantly (p<0.001) lower number of fruits compared to encapsulated P. fluorescens 100% and S. platensis 100%. Plants treated with encapsulated P. fluorescens 100% showed a significantly (p<0.001) higher number of fruits compared to S. platensis 100%. Other treatments showed no significant variability in the number of fruits.
Mean Weight of Fruits
 |
Figure 7: No: of Fruits vs Different Treatments |
No statistically significant variability in mean fruit weight was detected among plants when treated with different treatments.
 |
Figure 8: Mean Weight of Fruits vs Different Treatments |
Fresh Weight
A statistically significant (p<0.001) variability in fresh weight among plants when treated with different treatments. Plants treated with S. platensis 100% showed significantly (p<0.001) lower fresh weight compared to NPK and encapsulated P. fluorescens 100%. Plants treated with S. platensis 100% showed a significantly (p<0.001) higher fresh weight compared to the control. The control showed significantly (p<0.001) lower fresh weight compared to NPK and encapsulated P. fluorescens 100%. Other treatments showed no significant variability in fresh weight.
 |
Figure 9: Fresh Weight vs Different Treatments |
Dry Weight
A statistically significant (p<0.001) variability in dry weight among plants when treated with different treatments. Plants treated with S. platensis 100% showed significantly (p<0.001) lower dry weight compared to NPK and encapsulated P. fluorescens 100%. The control treatment showed significantly (p<0.001) lower dry weight compared to NPK and encapsulated P. fluorescens 100%. Other treatments showed no significant variability in fresh weight.
 |
Figure 10: Dry Weight vs Different Treatments |
Fresh Weight- Dry weight
A statistically significant (p<0.001) variability in fresh-dry weight among plants when treated with different treatments. Plants treated with control showed significantly (p<0.001) lower fresh-dry weight compared to NPK, encapsulated P. fluorescens 100%, and S. platensis 100%. NPK treatment showed significantly higher fresh-dry weight compared to encapsulated P. fluorescens 100%. Encapsulated P. fluorescens 100% treatment showed significant (p<0.001) reduction in fresh-dry weight compared to S. platensis 100%. Other treatments showed no significant variability in fresh weight.
 |
Figure 11: (Fresh-Dry) Weight vs Different Treatments |
 |
Figure 12: (T1) S. melongena, which served as the control plant. |
 |
Figure 13: (T2) S. melongena, added with NPK fertilizer (100%). |
 |
Figure 14: (T3) S. melongena with immobilized cells P. fluorescence (100%). |
 |
Figure 15: (T4) S. melongena, added with S. platensis (100%). |
Discussion
Bacterial species found in the rhizosphere, P. fluorescens, have been found to encourage plant growth in the past.29 Bacteria are drawn to the rhizosphere because it offers shelter, less competition from soil microorganisms, and the ability to consume plant-related exudates in exchange for its occupancy.23 The mechanisms of nitrogen fixation, ammonia excretion, phosphate solubilization,13 and growth hormone generation may be used to explain the rise in yield and yield characteristics brought on by the application of biofertilizer coupled with organic and commercial N fertilizer. The current study showed that when compared to NPK, the T3 (P. fluorescence given in the form of 100% immobilized cells) combination of biofertilizers was the best for improving brinjal growth using organic techniques. The most significant return is obtained from treatment T3, which also considerably enhances broccoli’s quality, production, and growth. Fertilizer and bacterium-treated plants grow more quickly than control plants. Notable changes in plant development were observed.26 In all fenugreek varieties tested, rhizospheric bacterial additions raised endogenous melatonin levels. In salt-stress situations, the use of ST-PGPR may not only reduce the dosage of mineral fertilizers but enhance the antioxidant and nutritional properties of therapeutic crops like wheatgrass.17 Under saline circumstances, treatment boosted chickpea’s antioxidant enzyme activity, facilitating detoxifying reactive oxygen and nitrogen species and limiting nitro-oxidative damage. Following salt stress, the PGPR-inoculated chickpea plants had an increased K+/Na+ ratio and amino acid proline content.5 P.putida has a more robust biocontrol capability than P.stutzeri, although P.stutzeri has more plant growth-stimulating activities.12 MDA, sodium, and chloride levels were lower in PGPR-inoculated salt-stressed tomato plants than in non-inoculated plants.
Maintaining crop growth and production may be possible with the combined use of PGPR and nanomaterials. Furthermore, various nanomaterials with PGPR, including titanium, gold, zeolites, carbon, zinc, silver, silica, etc., have positive effects on the growth of plants.4 Compared to drought-stressed, control, and plants that received just biochar and PGPR treatment, the plants that received co-application of biochar and PGPR showed superior improvement in nutrient absorption, leaf relative water content (RWC), and growth metrics. Furthermore, compared to those that were either treated alone or not at all, the co-application of PGPR and biochar resulted in more significant amounts of sugar, proteins, flavonoids, phenolic compounds, and enzymatic activity (POD, SOD, GR, and dehydroascorbate reductase14(DHAR). Agricultural production methods have traditionally employed plant growth-promoting rhizobacterial (PGPR) microorganisms, and mounting research indicates that these microbes might enhance plants’ tolerance to unfavourable environmental conditions.16 Moreover, using biochar to increase the soil’s ability to retain moisture is an additional strategy for raising agricultural output in drought-stricken areas.25 By suppressing the growth of phytopathogens through parasitism, competition for nutrients, and the production of antagonistic substances in the rhizosphere, such as HCN, extracellular hydrolytic enzymes, siderophores, ACC deaminase, salinity tolerance to plants, antibiotics, volatile organic compounds, and antimicrobial metabolites.19 The biocontrol action of polycyclic aromatic hydrocarbons (PGPRs) is attributed to several mechanisms, such as the prevention of plant diseases, biosurfactant synthesis, toxins, antibiotics, extracellular cell wall disintegrating hydrolytic enzymes, competition and aggression for nutrients, and colonisations.18
Furthermore, when exposed to salt stress, PGPR-treated plants had more excellent magnesium, calcium, potassium, phosphorus, and iron levels. By reducing the detrimental effects of salt stress on plant development, halotolerant PGPR strains can boost tomato yield and resistance to salt stress.28 Two genetic methods that show promise for managing black scurf7 include creating transgenic lines by overexpression or silencing of pathogenesis-related (PR) genes and genome editing to produce sequences with reduced susceptibility to the sickness. In a green setting, using PGPR increased plant growth while reducing stem nematode disease. Consequently, on an average of two years, PGPR increased farmer’s projected returns in the green system and increased production by 26.44%. Additionally, by adding 7.51% more soluble sugar and 14.30% more vitamin C, PGPR increased the product’s nutritional quality. The purple sweet potato’s anthocyanin content increased by 10.73%. One efficient method for increasing crop development is to treat plants with microbe-to-plant signal chemicals or inoculate them with plant-growth-promoting rhizobacteria (PGPR). These strategies can also improve crop resistance to abiotic stressors (including heat, salt, and drought), which are predicted to occur more frequently as the effects of climate change increase. Due to this discovery, multifunctional PGPR-based formulations have been developed to decrease the use of synthetic fertilisers and agrochemicals in commercial agriculture. Methods for enhancing the rhizosphere colonisation of PGPR inoculant are investigated. Researchers looked at how PGPR may be used in agriculture in the twenty-first century and how to commercialise a PGPR-based technology, both similar to current initiatives.2 Further research in this area is warranted, as successful biocontrol through antagonistic microbes necessitates a thorough understanding of the regulatory network and disease suppression mechanisms employed by antagonists, as well as host-associated bacterial communities that initiate colonisation during host responses.15
Conclusion
Current work shows that PGPR present throughout the root zone of vegetable genera has enormous plant probiotic potential. The rhizosphere’s high selection pressure may have promoted the emergence of PGPR with the substantial accumulation of plant-beneficial characteristics. As a result, the chosen isolates in this investigation were proven to function as plant probiotics for various plants employed under various circumstances. The identified organisms were scientifically evaluated for the production of IAA and then used to boost the development of several distinct crops. Unraveling the molecular biology of the reported outcomes might give further insight into plant-microbe interactions, which could be investigated further. Under infected circumstances, P.putida – treated plants showed significantly better defence-related enzymatic activity, growth, and yield.
Acknowledgment
I express my sincere gratitude towards Prof. Lizzy Mathew Research Guide, St. Teresa’s College, Kochi for her valuable suggestions and encouragement. I greatly acknowledge Dr. K. Surendra Gopal, Professor (Microbiology) Department of Agricultural Microbiology, College of Horticulture, Kerala Agricultural University, Vellanikkara, Thrissur, Kerala for their valuable help during the course of my work.
Conflict of Interest
Authors had declared, there was no competing interests.
Funding Sources
Research got no financial support for authorship and/or publication.
References
- Alexandratos N.and Bruinsma J. World Agriculture Towards 2030/2050: the 2012 Revision. ESA Working. 2012; Paper 12-03, FAO, Rome.
- Backer, R., Rokem, J. S., Ilangumaran, G., Lamont, J. Praslickova, D., Ricci, E., Subramanian, S., & Smith, D. L., Plant Growth-Promoting Rhizobacteria: Context, Mechanisms of Action, and Roadmap to Commercialization of Biostimulants for Sustainable Agriculture. Frontiers in plant science. 2018 ;(9): DOI:3389/fpls.2018.01473.
CrossRef - Bardgett R. D., Freeman C., and Ostle N., Microbial contributions to climate change through carbon cycle feedbacks. ISME J. 2008; (2): 805814. doi:10.1038/ismej.2008.58.
CrossRef - Basit, F., Bhat, J.A., & Guan, Y. Elucidation of Synergistic Interaction Among Metal Oxide Nanoparticles and PGPR on the Plant Growth and Development. In: Husen, A. (eds) Nanomaterials and Nanocomposites Exposures to Plants. Smart Nanomaterials Technology. 2023; Springer, Singapore. https://doi.org/10.1007/978-981-99-2419-6_16.
CrossRef - Basu S., Kumari, S., Subhadarshini P., Rishu A.K.,Shekhar S., andKumar G. Plant growth promoting rhizobacterium Bacillus BSE01 alleviates salt toxicity in chickpea (Cicer arietinum L.) by conserving ionic, osmotic, redox and hormonal homeostasis. Physiologia Plantarum.2023; (175): DOI: 10.1111/ppl.14076.
CrossRef - Berlanas C., Berbegal M., Elena G., Laidani , Cibriain J. F., Sagües A. et al. The fungal and bacterial rhizosphere microbiome associated with grapevine rootstock genotypes in mature and young vineyards. Front. Microbiol. 2019;(10):1142. doi: 10.3389/fmicb.2019.01142.
CrossRef - Chaudhary, S., Lal, M., Sagar, S. et al.Black scurf of potato: Insights into biology, diagnosis, detection, host-pathogen interaction, and management strategies. plant pathol. (2023). https://doi.org/10.1007/s40858-023-00622-4.
CrossRef - Drost S. M., Rutgers M., Wouterse M., De Boer W. and Bodelier, P. L.Decomposition of mixtures of cover crop residues increases microbial functional diversity. Geoderma. 2020; (361):114060. doi: 10.1016/j.geoderma.2019.114060.
CrossRef - Ho A., Ijaz U. Z., Janssens T. K., Ruijs R., Kim S. Y., De Boer W., et al. (2017). Effects of bio-based residue amendments on greenhouse gas emission from agricultural soil are stronger than effects of soil type with different microbial community composition. GCB Bioenergy. 2017;(9):1707–1720. doi:1111/gcbb.124 57.
CrossRef - Huang A. C., Jiang T., Liu Y.-X., Bai Y.-C., Reed J., Qu, B. et al. (2019). A specialized metabolic network selectively modulates Arabidopsis root microbiota. Science. 2019; 364:6389. doi: 10.1126/science.aau6389.
CrossRef - Janssens , Havlík P., Krisztin T., Baker J., Frank S., Hasegawa T., et al., Global hunger and climate change adaptation through international trade. Nat. Clim. Change. 2020; (10): 829–835. doi: 10.1038/s41558-020-0847-4.
CrossRef - Khan, A., and Bano A. and Khan R. A. and Khan, N. Role of PGPR in suppressing the growth ofMacrophomina phaseolina by regulating antioxidant enzymes and secondary metabolites in Vigna radiata Wilcze. South African Journal Of Botany.2023; (158):443-451.
CrossRef - Kumar V., Kumar Behl R., Narula N. Establishment of phosphate-solubilizing strains of Azotobacter chroococcum in the rhizosphere and their effect on wheat cultivars under green house conditions. Microbiological Research.2001; (156): 87-93.
CrossRef - Lalay, G., Ullah, A., Iqbal, N. et al.The alleviation of drought-induced damage to growth and physio-biochemical parameters of Brassica napus genotypes using an integrated approach of biochar amendment and PGPR application. Environ Dev Sustain .2022; https://doi.org/10.1007/s10668-022-02841-2.
CrossRef - Lahlali, R., Ezrari, S., Radouane, N., Kenfaoui, J., Esmaeel, Q., El Hamss, H., Belabess, Z., Barka, E.,A. Biological control of plant pathogens: a globalperspective.Microorganisms2022;10:596. https://doi.org/ 10.3390/microorganisms10030596.
CrossRef - Lizana, C., Wentworth, M., Martinez, J. P., Villegas, D., Meneses, R., Murchie, E. H., Pastenes, C., Lercari, B., Vernieri, P., & Horton, P. Differential adaptation of two varieties of common bean to abiotic stress: I. Effects of drought on yield and photosynthesis. Journal of Experimental Botany, 2006; 57, 685–697.
CrossRef - Mishra , Mishra, J. and Arora, N. K. Salt tolerant Pseudomonas taiwanensis PWR-1 in combination with a reduced dose of mineral fertilizers improves the nutritional and antioxidant properties of wheatgrass grown in saline soil. World Journal Of Microbiology \& Biotechnology. 2024; (40):DOI:10.1007/s11274-023-03806-x.
CrossRef - Mohanty, P, Singh, P.K., Chakraborty, D., Mishra, S., & Pattnaik, R. Insight into the role of PGPR in sustainable agriculture and environment. Front Sustain Food Syst 2021; 5:667150. https://doi.org/10.3389/fsufs.2021.667150.
CrossRef - Nagrale D, Gawande S, Shah V, Verma P, Hiremani N, Prabhulinga T, Gokte-Narkhedkar N & Waghmare V. Biocontrol potential of volatile organic compounds (VOCs) produced by cotton endophytic rhizobacteria against Macrophomina phaseolina. Eur J Plant Pathol 2022; 163(2):467–482. https://doi.org/10.1007/s10658-022-02503-z.
CrossRef - Nelson G. C., Valin H., Sands D., Havlík, P., Ahammad H. Deryng D., et al., Climate change effects on agriculture: economic responses to biophysical shocks. Proc. Natl. Acad. Sci. U.S.A. 2014;(111): 3274–3279. doi: 10.1073/pnas.1222465110.
CrossRef - Ojuederie O. B. and Babalola O. O. Microbial and plant-assisted bioremediation of heavy metal polluted environments: a review. J. Environ. Res. Public Health 2017;(14):1504. doi: 10.3390/ijerph14121504.
CrossRef - Ortíz-Castro R., Contreras-Cornejo H. A., Macías-Rodríguez L. and LópezBucio J. (2009). The role of microbial signals in plant growth and development. Plant signaling & behavior . 2009; (4): 701–712. doi: 10.4161/psb.4. 8.9047.
CrossRef - Pal K.K, Mc Spadden Gardener B. Biological Control of Plant Pathogens. The Plant Health Instructor. 2006; DOI: 10.1094/PHI-A-2006-1117-02.
CrossRef - Pareek A., Dhankher O. P. and Foyer C. H. Mitigating the Impact of Climate Change on Plant Productivity and Ecosystem Sustainability. 2020; Oxford: Oxford University Press UK. doi: 10.1093/jxb/erz518.
CrossRef - Qayyum, M. F., Abid, M., Danish, S., Saeed, M. K., & Ali, M. A. Effects of various biochars on seed germination and carbon mineralization in an alkaline soil. Pakistan Journal of Agricultural Sciences,2015; 51, 977–982.
- Qiao, Q., Wang, F., Zhang J., Chen Y., Zhang C., Liu, G. et al. The variation in the rhizosphere microbiome of cotton with soil type, genotype and developmental stage. Rep. 2017;(7): 1–10. doi: 10.1038/s41598-017-04213-7.
CrossRef - Raghvendra Pratap Singh, Saurabh Kasera and Devi Singh. Effect of Bio-fertilizers on Growth, Yield and Quality of Brinjal (Solanum melongena ) cv. Kashi Uttam.Chem Sci Rev Lett, 2020; 9 (35): 786-79.
- Reinhold-Hurek B., Bünger W., Burbano C. S., Sabale M. and Hurek T. Roots shaping their microbiome: global hotspots for microbial activity. Rev. Phytopathol.2015; (53): 403–424. doi: 10.1146/annurev-phyto-082712-102342.
CrossRef - Saleem M., Arshad M., Hussain S., Bhatti A.S. Perspective of plant growth promoting rhizobacteria (PGPR) containing ACC deaminase in stress agriculture. Journal of Industrial Microbiology & Biotechnology. 2007; (34): 635-648.
CrossRef - Singh and Kapoor K.K. Inoculation with phosphate solubilizing microorganisms and a vesicular arbuscular mycorrhizal fungus improves dry matter yield and nutrient uptake by wheat grown in a sandy soil. Biol. Fertil. Soils. 1998; (28): 139-144.
CrossRef

